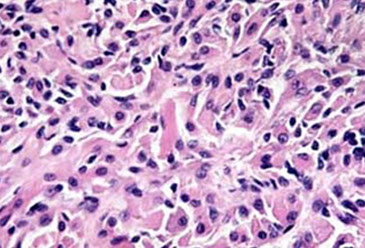

Larynx and Trachea
Branchial cleft anomaly
Laryngeal Papillomatosis (LP)
Proliferative Verrucous Leukoplakia (PVL)
Laryngeal Carcinoma
Granular Cell Tumor
Terms:
Pleomorphism - different cell components / types
Polymorphism - same cells but with different shapes?
Branchial cleft Cyst
From 2nd branchial cleft (>9/10)
- M=F, 3rd to 4th decades, lateral neck
DDx: met SCC (in older pts)
- just call it squamous lined cyst if not completely sure
Laryngeal Papillomatosis (LP)
- aka Juvenile laryngeal papillomatosis (?)
MC B9 neoplasm of larynx assoc HPV: type 6/11
- aggressive dz possibly assoc c type 16 and18
- can involve any portion of upper and lower resp
tract, but usually begins in glottis
- extension to bronchial tree and lung may be fatal, even in benign disease
- usually presents in infancy or early childhood;
however, identical lesions may appear at any age
- adult forms do not tend to spread and recur as extensively as childhood forms
Gross: Warty polypoid lesions from tiny to 1 or more cm in diameter
Micro: rounded papillary proliferations of nonkeratinizing sq epithelium. Minor areas of keratinization may be seen
- Clear koilocytotic change uncommon, but
minor cytologic atypia common
- Marked cytologic atypia, especially in children, does not necessarily imply malignant or premalignant change. In adults it is more worrisome
Tx: : endoscopic removal of gross lesions with
laser, may need to be done every few months
- Recent intralesional injection with anti-virals has shown great promise
Px: 2% incidence of carcinoma. 2-14% mortality;
2-15% extend into tracheobronchial tree. May regress at puberty or later
Proliferative Verrucous Leukoplakia (PVL)
rare, aggressive form of leukoplakia in older women with irreversible changes in oral cavity that usually progresses to Verrucous Carcinoma or SCC
Histo: well-defined lesion c hyperplastic epithelium c evenly spaced verrucous epithelial projections and assoc hyperkeratosis
Tx: surgery; rads does not help
Laryngeal carcinoma
* see Salivary Glands and Oropharynx for further discussion of SCC subtypes
assoc w EtOH, tobacco, HPV 6/11, radiation exposure, laryngeal reflux, prior injury from inhalation
MC presentationis hoarseness and cervical lymphadenopathy
- grossly, invasive SCC can look ulcerated, flat, exophytic, verrucoid or papillary
- MC cancer is Squamous cell carcinoma on the true vocal cords
- common upper airway malignancy affecting speech, swallowing, and breathing
Dx: laryngoscopy w tissue bx
- CT/MRI determines extent of dz and mets
- b/c of rich vascular supply may cause hemorrhage/ aspiration
Micro:
- definition of severe dysplasia is broader in laryngeal glottis than other parts of body
- may see granulomatous rxn to keratin produced
- desmoplastic response is characteristic of invasive ca
Tx: early stage: surgical removal of microinvasive laryngeal glottic lesions has same behavior as severe dysplasia
- however, supra-glottic microinvasive ca is metastatic in 1/5 cases
Advanced stage: rads + chemo
Late stage: Total laryngectomy, reconstruction, adjuvant post-op chemoradiation
Papillary (exophytic) SCC
solitary exophytic lesion, M>F, older adults, in larynx (MC), oral mucosa, hypopharynx and sinonasal tract, possible assoc c HPV
- considered invasive even in absence of definite stromal invasion
- Tx: surgical
- Px: similar to conventional SCC
-- ddx: should RO laryngeal papillomatosis
Granular cell tumor
B9 (usually), Schwann cell origin, seen in skin, tongue, larynx, F > M, young adults
- presents as painless mass
Micro: pseudoepitheliomatous hyperplasia, may mimic SCC
- tumor cells c eosinophilic granular cytoplasm
and round centrally placed nucleoli
- Not encapsulated, may appear infiltrative and involve nerves
- malignancy rare; they are more cellular, with nuclear pleomorphism, necrosis, mitotic activity and have prominent nucleoli
IHC: PAS – D+
- granules = lysosomes. S100, CD 68+
DDx: paraganglioma and alveolar soft part sarcoma
Tx: surgical excision for benign lesions
Rhabdomyoma (adult type)
B9 tumor of sk muscle; less common than rhabdomyosarcomas. M > F; >40 yo
- in neck, pharynx, larynx, tongue, FOM, soft palate
Gross: Well-circ, not encapsulated, brown
tumor, resembling muscle
Micro: Large polygonal cells c fibrillar eosinophilic
cytoplasm, often with cross-striations. One or two nuclei usually at periphery of cell
IHC: (+) Desmin, actin, myoglobin and other
muscle markers
DDx: Granular cell tumor, alveolar soft part sarcoma.
Tx: Cured by complete surgical excision.
Contact ulcer of the larynx
B9 ulcerative lesion, produces nodule
- caused by entubation, voice abuse, GE reflux
- M > F, generally adults; MC site along posterior aspect of one or both true vocal cords
- sx: hoarseness, dysphagia, dysphonia, obstruction, choking
Gross: ulcerated polypoid mass up to 3 cm in diameter
Micro: ulcerated mucosa with underlying florid
granulation tissue with radiating vascular pattern
- Stromal cells may be plump and endothelial cells may be large
DDx: spindle cell carcinoma (sarcomatoid carcinoma) of the larynx
Tx: treat underlying cause.
Vocal Cord Nodule
Non-neoplastic stromal reactions that occur on true vocal cord in response to trauma, such as voice abuse in singers and auctioneers
Micro: can have submucosal myxoid material c vascular stroma, fibrous tissue deposition, prominent dilated vascular spaces, and deposition of dense hyaline material / fibrin
Spindle cell carcinoma of the larynx
SCC c sarcomatoid pattern; can occur in other mucosal sites of upper respiratory tract; larynx most common.
- 4M>1F. 6th - 8th decades; no specific correlation of
this pattern with risk factors; some in area of prior
irradiation
Usually exophytic or polypoid 1-6 cm in diameter. Often do not invade deeply or extend into extralaryngeal soft tissue
- arise from anterior aspect of vocal cord unlike
contact ulcer
Micro: Spindle cells or pleomorphic cells with high
cellularity and high mitotic rate, may have areas of
osseous or cartilaginous differentiation. Look for areas of SCC or overlying dysplasia.
IHC: +/- CK
DDx: Inflammatory Myofibroblastic Tumor (ALK+)
Primary sarcomas (except well-differentiated chondrosarcomas of the laryngeal skeleton) are rare
Tx: excision; rads may be depending on stage
Px: generally poor, but the polypoid vocal cord lesions may do better





PVL


Granular cell tumor

Rhabdomyomas (in dogs)

Spindle cell carcinoma. 1a: Spindle cell lesion with myxoid stroma (HE ×200). 1b: Mild to moderate atypia in tumor cells with rare mitoses (HE ×400). 1c: Vimentin immunoperoxidase – strong expression in tumor cells (×400). 1d: Pan-cytokeratin AE1/3 immunoperoxidase (×400). 1e: smooth muscle actin immunoperoxidase (×400). 1f: Proliferation (Ki67) up to 80% (immunoperoxidase ×200). [1]
Vocal cord nodule


References
1. Ullrich et al. Differential diagnosis of laryngeal spindle cell carcinoma and inflammatory myofibroblastic tumor – report of two cases with similar morphology. Diagnostic Pathology 2007.
